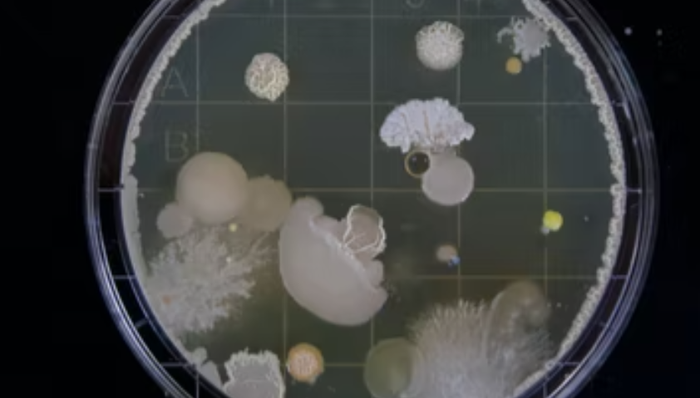
化妆品原料,产品创新,微生物

文|聚美丽 诗 诗
原料创新,是推动化妆品行业产品创新的重要源泉。虽然,原料所属的科学领域发展规律,决定了一款新原料往往研发周期很长、更新迭代频率低,但与此同时,原料的研发创新也具备相当广阔的空间,吸引科研人员不断探索前行。
国外原料公司,尤其是跨国公司对原料市场趋势一向有较强的话语权,这来源于他们经年累月的研发经验与成果。同时,基于市场需求的变化,他们也通过结构修饰、技术改良等方式进行原料升级,并在可持续发展的共识下,结合不同的护肤理念开发出具有特殊护肤功效的新原料。
而国内,自新规实施以来,国家药监局先后通过了多个国产新原料的备案。整个化妆品行业对新原料成分、配方的研发也愈加重视,形成一股“侧重科研技术”的新趋势。
在这样的背景下,成分特辑推出全新子栏目“原料新品”,意在以国内外新原料研发动态、新品介绍为主题,进行持续报道。欢迎大家关注收藏!
本期的原料新品主题是,与皮肤微生态概念有关的原料成分。随着“皮肤微生态”作为一个新的理念在护肤领域的热度越来越高,对应的新原料也不断开发迭代,提供给品牌们更多选择。

01 巴斯夫:接触水分会复苏的“活益生菌”
今年6月份,巴斯夫个人护理团队通过相同的生物发酵工艺,开发了两种化妆品成分:Probiolift (INCI:麦芽糖糊精、乳酸杆菌)和 Postbiolift (INCI:麦芽糖糊精、乳酸杆菌发酵产物)。据巴斯夫称,该系列原料是首次利用了卷曲乳杆菌的护肤原料,这种益生菌天然存在于人体皮肤表面。

图片来源于巴斯夫官网
研究发现,随着年龄的增长,人体皮肤表面的乳酸菌数量会明显减少。其中,革兰氏阳性菌和棒状厌氧卷曲乳杆菌的变化最显著。因此,巴斯夫的团队猜测,皮肤上的卷曲乳杆菌可能在皮肤健康和年轻化中扮演着重要角色。
据了解,Probiolift 由处于休眠状态的卷曲乳杆菌制成,这种益生菌和皮肤上的水分接触时会苏醒。在女性志愿者的临床试验中,含有0.05%Probiolift 的配方能够使皮肤更加饱满年轻、改善前额皱纹。
而Postbiolift 是一种后生元成分,含有卷曲乳杆菌分泌的有益代谢物。试验表明,其能够增强皮肤弹性,改善女性鱼尾纹,以及色素性老年斑。
事实上,无论是益生菌、益生元还是后生元,都对皮肤有比较大的益处。但是,将活的益生菌融入化妆品配方中还面临一些挑战。在技术层面,要通过一定的方法来保持益生菌的活性;而在合规层面,是否能在化妆品中应用“活菌”还需要研判和慎重考量。因此,对“活菌”的开发与利用,目前在个人护理行业中确实不容易。
不过,对于研发的原料,巴斯夫表示:“Probiolift 成分可以安全地融入护肤产品中,同时不影响产品的保质期。在生物美容行业,该成分创造了前所未有的潜能。”
02 Expanscience:用于护肤和私处护理的益生元成分
Laboratoires Expanscience(以下简称“Expanscience”)由法国药剂师于1950年创立,这是一家专注于皮肤病理学、功效护肤品和化妆品活性成分的制药实验室,旗下拥有知名婴儿护理品牌Mustela妙思乐。
今年3月,Expanscience推出了一种可用于私处护理的新活性成分 Calybiota Bio(INCI名:甘油、红木棉花提取物、水)。该成分提取自西非红木棉树 ( Bombax costatum )的花萼,是一种富含多糖的益生元,可用于平衡皮肤微生物群。
研究表明,阴道微生物群由 90% 的乳酸菌(乳酸杆菌)组成。它们具有非常特殊的功能:刺激局部免疫系统并形成生物膜保护屏障;将生殖器粘膜细胞分泌的糖原转化为乳酸,维持阴道 pH 值在 3.5-4.5 的酸性环境。
阴道 pH 值反映了阴道微生物群的健康状况:pH 值高于 4.5 表明阴道菌群失衡,也称为生态失调。生态失调可能伴有异常分泌物、瘙痒或外阴疼痛等症状,有时会导致阴道感染。此外,不同类型的乳酸杆菌会根据荷尔蒙、生活习惯、外界因素等发生数量变化。
体外研究证明,Calybiota Bio能够为促进阴道健康的乳酸杆菌菌群(加氏乳杆菌、嗜酸乳杆菌、鼠李糖乳杆菌、卷曲乳杆菌和詹氏乳杆菌)补充营养物质,发挥益生元作用;同时,其对两种致病菌株:阴道杆菌和大肠杆菌具有抑菌、抗菌作用。
此外,Calybiota Bio能够减少表皮细胞(IL1α、PGE2、IL1β 和 TNFα)的许多炎症介质,发挥抗炎作用。而除了平衡阴道菌群之外,Calybiota Bio 也适用于皮肤粉刺、特应性皮炎、湿疹或过敏皮肤,以及除臭剂配方。
在特应性皮炎中,Calybiota Bio 能够保护表皮免受与金黄色葡萄球菌相关的发病机制;在痤疮和脂溢性皮炎中,它通过抑制致病菌株痤疮杆菌和糠秕杆菌来重新平衡皮肤微生物群;Calybiota Bio 还可减少与干燥衣原体、纹状体和表皮葡萄球菌菌株相关的腋臭,具有除臭应用潜力。

图片来源于Expanscience官网
03 LipoTrue:“海洋发酵剂”用于调节情绪压力
今年4月,来自西班牙的化妆品活性成分供应商LipoTrue推出了新的活性物Telessence Breeztel (INCI 名称:甘油、水、微球菌裂解物),这是一种海洋发酵剂。据称,微球菌是从汤加群岛(斐济岛)附近海风中收集的微生物,其发酵产物有助于驱散情绪压力。
经过LipoTrue的研究,影响皮肤的压力可分为3种不同的类型:环境压力、身体压力和情绪压力,这些压力源会加速生物衰老。对此,LipoTrue采用了3种不同的技术提取了3种活性成分,其中,Telessence Breeztel 主要用于对抗情绪压力。
LipoTrue官网公开的研究表明,情绪压力与皮肤中的皮质醇和 SP(注:神经末梢释放的一种神经肽,参与皮肤局部免疫炎症反应)增加有关。而Telessence Breeztel 能够调节皮质醇和 SP 的释放,并阻止由端粒缩短引发的细胞生物学衰老,通过修复和恢复表皮、真皮层的情绪因子,消除皮肤的情绪压力。
在临床人体试验中,有情绪压力的志愿者在使用2%的Telessence Breeztel 的面霜后,28 天内,她们的腿部皮肤含水量增加 72%;手臂和腿部皮肤的弹性增加 16%,紧致度增加 9%;1 小时内,皱纹深度淡化了 31%。

志愿者使用含有 2% Telessence Breeztel 面霜的照片(图片来源于LipoTrue官网)
04 亚什兰:保护皮肤微生物的除臭剂
去年10月份,亚什兰推出了新的原料产品sensidin pure skin multifunctional(INCI名称:丙二醇、奥替尼啶盐酸盐)。据悉,该产品能够以极低的使用浓度,提供强效、快速的抗异味细菌功效,同时不破坏个体微生物组。
汗液本身是无味的,但是在被微生物(主要是棒状杆菌)分解后,其中的蛋白质和脂质会转化成小分子挥发性的硫醇和脂肪酸,这些物质具有难闻的气味,是体味的主要来源。
人们一般通过两种主要产品来控制体味,一种是止汗剂,它可以阻止出汗,减少体味;另一种是除臭剂,它不会影响个体的排汗量,但会减少体味。然而,目前来看,不管是止汗剂还是除臭剂,基本都会影响到皮肤微生物丰富度。
根据亚什兰官网信息,sensidin 由具备出色抗菌性能的活性成分奥替尼定 HCl和一种广为接受的天然保湿剂 1,3-丙二醇组成。其能够快速抑制皮肤上引起异味的细菌的生长和繁殖,同时保护皮肤微生物群的个体多样性,对皮肤更加温和。
为了证明该产品的具体功能,亚什兰将sensidin 与其它除臭剂(如三氯生和柠檬酸三乙酯)进行了对比测试。结果表明,0.03% 浓度的sensidin 在10分钟内就能够对引起异味的表皮葡萄球菌和酵母马拉色菌起到显著功效。

细菌减少测试结果(图片来源于亚什兰官网)
微生物组不仅在皮肤健康中发挥着重要作用,而且与免疫系统、皮肤屏障等密切相关,保护皮肤微生物群已经成为个人护理产品中的一个重要理念。
因此,亚什兰也评估了含有 0.15% sensidin 除臭剂对腋窝微生物组的影响。结果显示,应用除臭剂48小时前后,两个区域的基线没有发生差异,该产品不会破坏皮肤健康的微生物群,能够保证对皮肤的温和安全。

皮肤微生物分类组成属前后对比结果(图片来源于亚什兰官网)
05 Rahn:增强皮肤屏障的小米发酵液
来自瑞士的特种化学品公司 Rahn 拥有“能源固化”和“化妆品活性物”两个部门,该公司于去年9月推出了新的后生元产品:DEFENSIL -PURE(INCI名:水、黍籽(小米)提取物、发酵乳杆菌、苯甲酸钠、山梨酸钾)。
据官网介绍,该产品是一种水基发酵小米提取物,其生产方式与酵母面包非常相似,针对干燥皮肤,提供保湿、强化皮肤屏障的作用,同时能够促进健康的皮肤微生物群。
据悉,干燥皮肤在受到物理损伤后,皮肤屏障功能会减弱,细菌更容易进入角质层,从而激活炎性体、引起不良炎症反应。
Rahn 使用了经过优化调整参数的发酵工艺,从一种有机金小米( organic gold millet )中获得后生元发酵产物。据称,与普通小米提取物相比,DEFENSIL -PURE中包含更多矿物质等活性物。
该公司表示,DEFENSIL -PURE除了用于平衡皮肤微生物群、强化皮肤屏障之外,也能够改善肤色、对抗特应性皮炎。

DEFENSIL -PURE的作用通路(图片来源于Rahn官网)
在体外研究中,DEFENSIL -PURE表现出抑制炎症小体激活的功能。而且,它能够进一步促进皮肤表面有益菌的生长,比如增加表皮葡萄球菌的丰度,取代不利于皮肤健康的微生物。同时,其能够保护有特应性皮炎的皮肤免受损害,增加皮肤水分,并重新建立皮肤屏障的保护功能。

评论